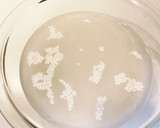

博多住み義母のたらこおこわ
めーめー0516 @cook_40281779
たらこは明太子でもいけます!
このレシピの生い立ち
博多住みのなのに明太子でなくたらこが好きな義母に教わったもの。餅米を水に浸す30分はありますが、あとはレンジのみでできる超簡単おこわ。
作り方
- 1
もち米2カップを30分水に浸してあげる
- 2
たらこ80gと酒大さじ1をときのばしておく
- 3
①に水350cc、塩小さじ1/2と②を加え、ラップをふんわりかけてレンジ500wで18分チン
- 4
10分蒸らしてできあがり
コツ・ポイント
もち米1カップの時はレンジ10分、蒸らし10分
似たレシピ

メスティン de 簡単たらこおこわ♪
メスティンを使うのだから、とっても簡単、を目指しました♪


香りがたまらない♡明太バターおこわ
だしの効いたモチモチおこわに明太バターの香りが最高〜♡たらこスパのおこわ版って感じ♪合わない訳がないです♪( ´▽`)


黒豆おこわ
ほんのり赤紫の黒豆おこわ黒豆は一晩戻すだけで手間いらず。程よい固さと甘さの黒豆が絶品!


銀杏おこわ
冬の終わりは、銀杏が余る。おこわにすると、柔らかい美味しい銀杏に。銀杏割が下手でも、美味しくなる。

さつまいもおこわ
さつまいもをもち米と一緒に炊飯器で炊き込んだシンプルなご飯です。

さつま芋おこわ
メディカル・ケア・サービス㈱が運営している施設で私たち栄養士が実際提供している献立です。


銀杏おこわ
我が家では銀杏と言えばコレ☆ほんのりとした甘さ&もちもちした食感。蓋を開けた瞬間フワ~ッ♡と銀杏の香り。たまりません♡


さつまいものおこわ
土鍋でじっくり炊いたさつまいもは甘味が増しておいしいです!もち米との相性もいいですね~

あさりおこわ
あさりの美味しい「だし」を、もち米にしっかりと吸わせてから蒸します!かみしめるほどに、じんわり美味しさが広がります!

大根葉のおこわ
大根葉の栄養たっぷり


もっちもち♪新じゃがのおこわ
ころころの小さな新じゃがを丸ごと炊き込んだごはんです。もちもちで食べごたえあり!


栗と鮭のおこわ
海と山の秋の味覚をおこわにしました。ご飯もちもち、栗はホクホク、ほのかな塩味で美味しいです。

落花生さんおこわ
落花生でおこわなんぞいかがでしょう(。-∀-)ニヒ♪落花生の甘みと香ばしさががおいしい☺


さつまいもごはん(おこわ)
祝☆人気検索トップ10入り【2121.12】マイフォルダー110人子どもたちが大好き。たくさん冷凍して、公園でも。


サツマイモの炊きおこわ
サツマイモをお米と一緒に炊くと甘くて大好きなんです。もち米だけで作りました。モチモチだよ(´∀`)♪


ホクホクさつまいものおこわ♪
炊飯器で簡単に♪シンプルな味でさつまいもの甘みたっぷりのおこわです♪


くるみおこわ
炊飯器にレシピの順に入れてスイッチオンでできあがり!くるみは、炊く時に入れるとしっとり、おこわも艶やかに仕上がります。


ふっくら黒豆おこわ
黒豆のおこわはふっくらとした豆と香りが楽しめます。おにぎりにもオススメです。


桜えびと人参のおこわ…
炊飯器におまかせのレシピ^^えびの香りと甘さが感じられるおこわです!色鮮やかなので…お祝い事にもつかえるかな。。。


黒豆おこわ
もち米と黒豆があればすぐ出来ます♪


さつまのおこわ
さつまいもの甘みをいかした”ほっこりおこわ”


秋のおこわ
栗がないときは、さつまいもでもOK!※写真はさつまいもで作りました。


さつまいものおこわ
1合の分量です。さつまいもの甘さが引き立ちほんのり醤油の香りがします。お弁当にも良いですよ^^


さつま芋おこわ
黒ゴマ塩なかったので 白炒りゴマをパラパラ♪ホッコリ優しい味で 秋を感じられます^^

茄子おこわ
茄子たっぷりの、もち米で炊く混ぜご飯です。


レンジでトウモロコシおこわ
生トウモロコシを使ったおこわです。「おこわ」はレン炊の得意技。もち米を30分浸して「炊飯土鍋なごみ」で加熱後蒸らすだけ。


さつま芋おこわ
ほっこりするシンプルな味☆甘くてもちもち!

さつまいもおこわ
炊飯器で簡単おこわ


さつまいものおこわ
さつまいもの美味しいシーズンです。もち米も一緒に炊いてもちもち食感のおこわにしました。

♡さつまいもおこわ♡
冷暗所で長く保存できて美味しいさつまいもを使った我が家の定番レシピです♡

その他のおすすめレシピ
https://cookpad.wasmer.app/jp/recipes/20538082